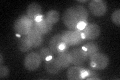
YNL166C
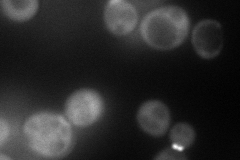
YNL166C
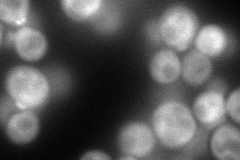
YNL166C
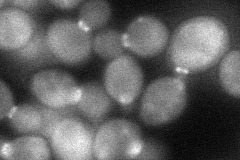
YNL166C
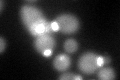
YNL166C
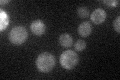
YNL166C

View description
Protein involved in organization of septins at the mother-bud neck, may interact directly with the Cdc11p septin, localizes to bud neck in a septin-dependent manner
Localization:
Intensity:
Fold change:
Significance:
-
C’ GFP library in SD
cytosol:bud neckN/A -
N' NOP1pr-GFP in SD
bud neck90.7682 -
N' TEF2pr-mCherry in SD
bud neck133.264 -
N' NATIVEpr-GFP in SD

bud neck44.0073 -
N' TEF2pr-VC and Cyto-VN in SD
cytosol,bud neck49.701 -
C’ GFP library in SD+DTT
cytosol.bud neck41.451.19No -
C’ GFP library in SD+H2O2

cytosol.bud neck37.041.07No -
C’ GFP library in Starvation Media
cytosol24.260.7No -
C’ GFP library on the background of Pup2-DaMP

cytosol:bud neck -
C’ GFP library on the background of CCT mutant

cytosol:bud neck36.87551.06706No
